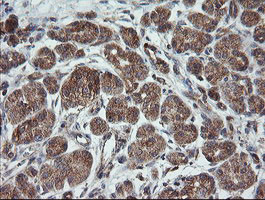
TRAPPC4 Antibody in Immunohistochemistry (Paraffin) (IHC (P))

Search
OriGene
TRAPPC4 Monoclonal Antibody (OTI2G8), TrueMAB™
{{$productOrderCtrl.translations['antibody.pdp.commerceCard.promotion.promotions']}}
{{$productOrderCtrl.translations['antibody.pdp.commerceCard.promotion.viewpromo']}}
{{$productOrderCtrl.translations['antibody.pdp.commerceCard.promotion.promocode']}}: {{promo.promoCode}} {{promo.promoTitle}} {{promo.promoDescription}}. {{$productOrderCtrl.translations['antibody.pdp.commerceCard.promotion.learnmore']}}
产品信息
TA505599
种属反应
宿主/亚型
分类
类型
克隆号
抗原
偶联物
形式
浓度
规格
纯化类型
保存液
内含物
保存条件
运输条件
靶标信息
TRAPPC4 is part of the multisubunit TRAPP (transport protein particle) complex and interacts with SDC2. It may play a role in vesicular transport from endoplasmic reticulum to Golgi. TRAPP proteins are involved in tethering during vesicle transport.
仅用于科研。不用于诊断过程。未经明确授权不得转售。
篇参考文献 (0)
生物信息学
蛋白别名: Hematopoietic stem/progenitor cell protein 172; similar to Caenorhabditis elegans F36D4.2 gene product; Synbindin; trafficking protein particle complex 4; Trafficking protein particle complex subunit 4; TRS23 homolog; unnamed protein product
基因别名: CGI-104; HSPC172; NEDESBA; PTD009; SBDN; SYNBINDIN; TRAPPC4; TRS23
UniProt ID: (Human) Q9Y296
Entrez Gene ID: (Human) 51399